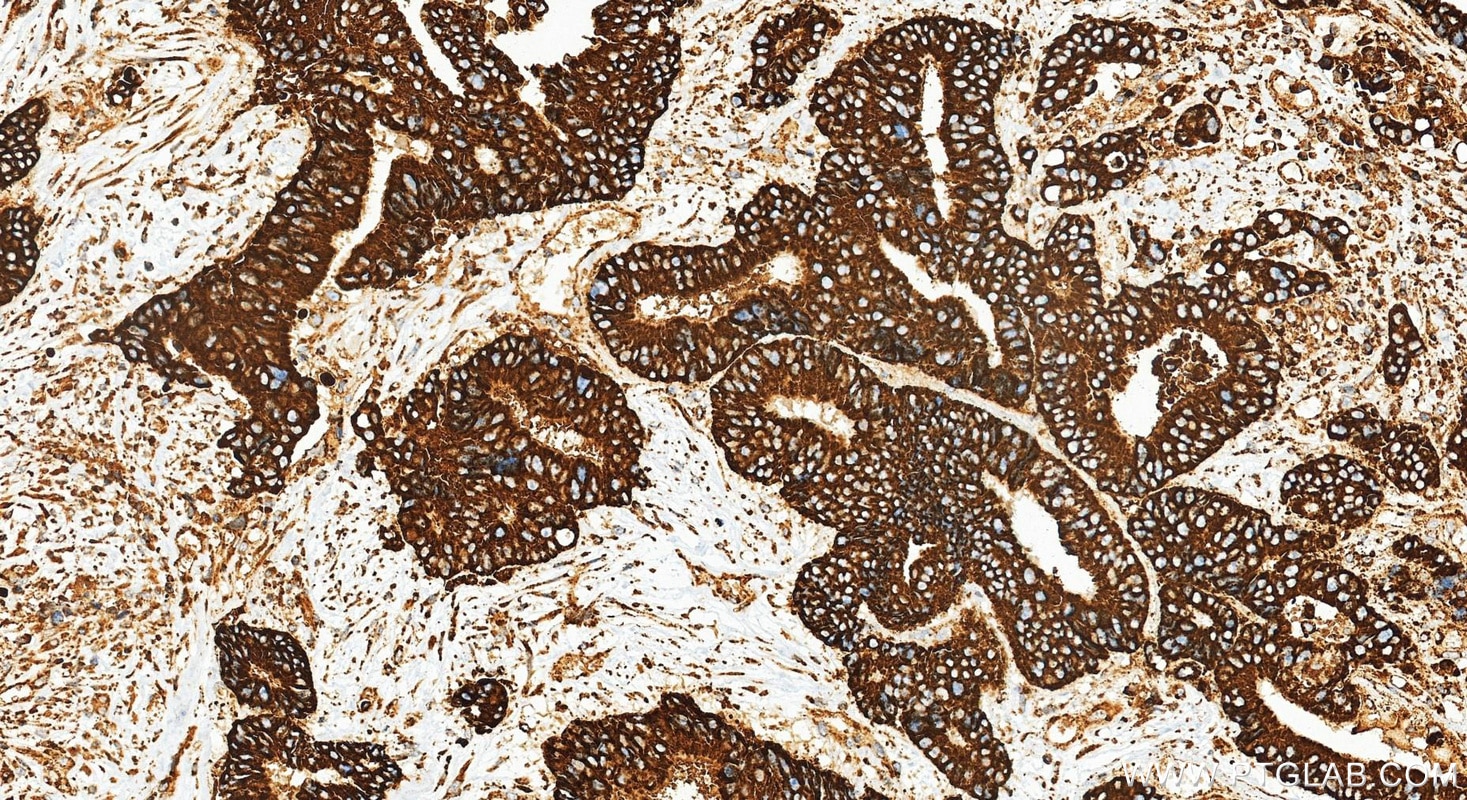
Immunohistochemical analysis of paraffin-embedded human colon cancer tissue slide using 83959-5-RR (XBP1S-specific antibody) at dilution of 1:1000 (under 20x lens). Heat mediated antigen retrieval with Tris-EDTA buffer (pH 9.0). Immunohistochemistry (IHC) staining of human colon cancer tissue using XBP1S-specific Recombinant monoclonal antibody (83959-5-RR)

Validation Data Gallery
Tested Applications
| Positive WB detected in | HeLa cells, HuH-7 cells, Raji cells, HEK-293T cells, MCF-7 cells, mouse liver tissue, rat liver tissue |
| Positive IHC detected in | human colon cancer tissue Note: suggested antigen retrieval with TE buffer pH 9.0; (*) Alternatively, antigen retrieval may be performed with citrate buffer pH 6.0 |
| Positive FC (Intra) detected in | Ramos cells |
Recommended dilution
| Application | Dilution |
|---|---|
| Western Blot (WB) | WB : 1:5000-1:50000 |
| Immunohistochemistry (IHC) | IHC : 1:500-1:2000 |
| Flow Cytometry (FC) (INTRA) | FC (INTRA) : 0.25 ug per 10^6 cells in a 100 µl suspension |
| It is recommended that this reagent should be titrated in each testing system to obtain optimal results. | |
| Sample-dependent, Check data in validation data gallery. | |
Published Applications
| WB | See 2 publications below |
Product Information
83959-5-RR targets XBP1S-specific in WB, IHC, FC (Intra), ELISA applications and shows reactivity with human, mouse, rat samples.
| Tested Reactivity | human, mouse, rat |
| Cited Reactivity | human |
| Host / Isotype | Rabbit / IgG |
| Class | Recombinant |
| Type | Antibody |
| Immunogen |
CatNo: Ag21703 Product name: Recombinant human XBP1 protein Source: e coli.-derived, PGEX-4T Tag: GST Domain: 167-376 aa of BC000938 Sequence: GAGPVVTPPEHLPMDSGGIDSSDSESDILLGILDNLDPVMFFKCPSPEPASLEELPEVYPEGPSSLPASLSLSVGTSSAKLEAINELIRFDHIYTKPLVLEIPSETESQANVVVKIEEAPLSPSENDHPEFIVSVKEEPVEDDLVPELGISNLLSSSHCPKPSSCLLDAYSDCGYGGSLSPFSDMSSLLGVNHSWEDTFANELFPQLISV 相同性解析による交差性が予測される生物種 |
| Full Name | X-box binding protein 1 |
| Calculated molecular weight | 261 aa, 29 kDa |
| Observed molecular weight | 60 kDa |
| GenBank accession number | BC000938 |
| Gene Symbol | XBP1 |
| Gene ID (NCBI) | 7494 |
| RRID | AB_3671537 |
| Conjugate | Unconjugated |
| Form | |
| Form | Liquid |
| Purification Method | Protein A purfication |
| UNIPROT ID | P17861 |
| Storage Buffer | PBS with 0.02% sodium azide and 50% glycerol{{ptg:BufferTemp}}7.3 |
| Storage Conditions | Store at -20°C. Stable for one year after shipment. Aliquoting is unnecessary for -20oC storage. |
Background Information
XBP1, also named as XBP2, belongs to the bZIP family. The X-box-binding protein-1 (XBP1) is a transcriptional regulator of the ER stress response that lies downstream of inositol-requiring enzyme 1 (IRE1α) activation (PMID: 14559994). XBP1 localizes in the nucleus. As a transcription factor, it is essential for hepatocyte growth, the differentiation of plasma cells, the immunoglobulin secretion, and the unfolded protein response. XBP1 has an association with major affective disorder. The unspliced XBP1U isoform is composed of 261 amino acid residues, and the spliced XBP1S isoform is composed of 376 amino acid residues. The calculated molecular weight of protein generated from the unspliced XBP1 isoform XBP1U mRNA is 33 kDa, and protein generated from spliced XBP1 isoform XBP1S mRNA is 54 kDa. This antibody specially recognizes the XBP1S isoform.
Protocols
| Product Specific Protocols | |
|---|---|
| IHC protocol for XBP1S-specific antibody 83959-5-RR | Download protocol |
| WB protocol for XBP1S-specific antibody 83959-5-RR | Download protocol |
| Standard Protocols | |
|---|---|
| Click here to view our Standard Protocols |
Publications
| Species | Application | Title |
|---|---|---|
Am J Physiol Cell Physiol Inhalation Exposure to Airborne PM2.5 Attenuates Hepatic Metabolic Pathways through S-Nitrosylation of the Primary ER Stress Sensor | ||
Free Radic Biol Med Ultrasound-Responsive Taurine Lipid Nanoparticles Attenuate Oxidative Stress and Promote Macrophage Polarization for Diabetic Wound Healing |